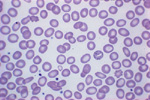
Γονιδιακή θεραπεία οδηγεί στην εκρίζωση της μεσογειακής αναιμίας

Γονιδιακή θεραπεία οδηγεί στην εκρίζωση της μεσογειακής αναιμίας
Αθήνα: Ελπίδες για τους πάσχοντες από μεσογειακή αναιμία δημιουργεί μια νέα γονιδιακή θεραπεία, η οποία στοχεύει στη διόρθωση της γενετικής βλάβης, αντικαθιστώντας το παθολογικό γονίδιο με άλλο υγιές, χωρίς να απαιτείται καταστολή του μυελού των οστών.

Αριθμός Πιστοποίησης Μ.Η.Τ.232442
Αριθμός Πιστοποίησης Μ.Η.Τ.232442